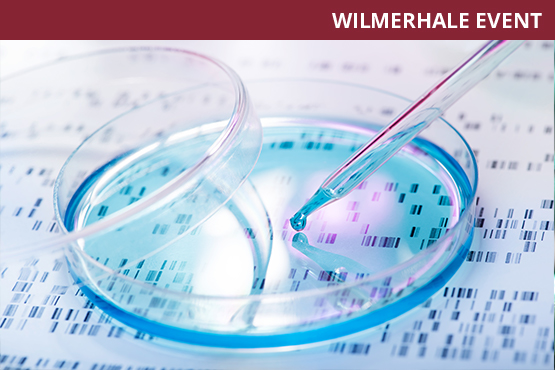
18_QuickLaunch_PrivateMarket_May_1

WilmerHale Webinar: Cross-Border Life Sciences Collaborations in China – Part 2
- 5.30.2018 | 10:00 AM - 11:00 AM
An increasing number of life sciences companies are seeking strategic partnerships and collaborations in markets across the globe. Many businesses have found opportunities for growth in China, thanks in part to regulatory reforms, government support and increased investor interest, which have created a favorable environment for biotech innovation.
On May 30, Partners Lester Ross and Kenneth Zhou from WilmerHale's Beijing office will continue our previous discussion of the licensing and legal environment in China for life sciences companies, including a discussion of the legal framework and government reorganization, and recent reforms in the Chinese Food and Drug Administration (CFDA) and the broader Chinese health regulatory system.
Other topics will include:
- risks and considerations of commercialization in China, including drug pricing; the process to receive payments outside China, and the tax and timing challenges;
- key licensing issues during negotiations;
- best practices for the cross-border flow of clinical data; and
- an update on the simplified clinical trial process for new drug applications.
*CLE credit is not available for those who watch webinar recordings.


